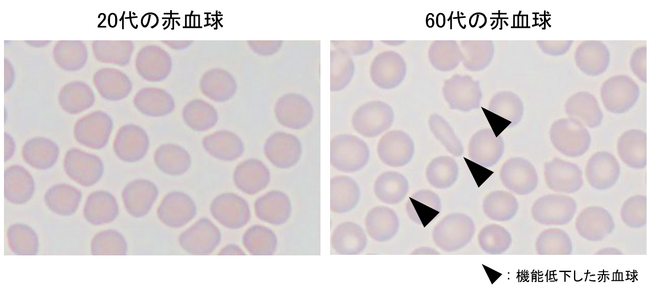
加齢に伴う疲れやすさに赤血球の機能低下が関与することを発見

日本メナード化粧品 総合研究所のプレスリリース(ページ 3)
老化細胞から分泌されるタンパク質が肌の再生を阻害することを発見 ~新品種の米から抽出したエキスが肌の再生を促す~
- 発表会社
- 日本メナード化粧品 総合研究所
- 配信日時
- 2023-11-29 10:30:00
- 配信元
- PR TIMES
シミの深部へアプローチする独自成分を開発 幹細胞に働きかけ、真皮へのメラニンの蓄積を防ぐ「ユキツバキエキス」
- 発表会社
- 日本メナード化粧品 総合研究所
- 配信日時
- 2023-09-05 10:30:00
- 配信元
- PR TIMES
日本メナード 日本初! 有効成分VEP ーMを配合したシワ改善美容液「薬用ラインズリセット〈医薬部外品〉」を発売
- 発表会社
- 日本メナード化粧品 総合研究所
- 配信日時
- 2023-08-21 10:30:00
- 配信元
- PR TIMES
日本メナード化粧品、安定化ビタミンE誘導体『VEP-M』がコラーゲンの減少を防ぐことを発見
- 発表会社
- 日本メナード化粧品 総合研究所
- 配信日時
- 2023-05-16 10:30:00
- 配信元
- PR TIMES
幹細胞による肌の再生が始まる“きっかけ”を発見 老化細胞が除去されたことを幹細胞が感知する
- 発表会社
- 日本メナード化粧品 総合研究所
- 配信日時
- 2023-05-11 10:30:00
- 配信元
- PR TIMES
日本メナード化粧品、“シワを改善する”安定化ビタミンE誘導体で医薬部外品の新規有効成分としての承認を取得!
- 発表会社
- 日本メナード化粧品 総合研究所
- 配信日時
- 2023-04-14 10:30:00
- 配信元
- PR TIMES